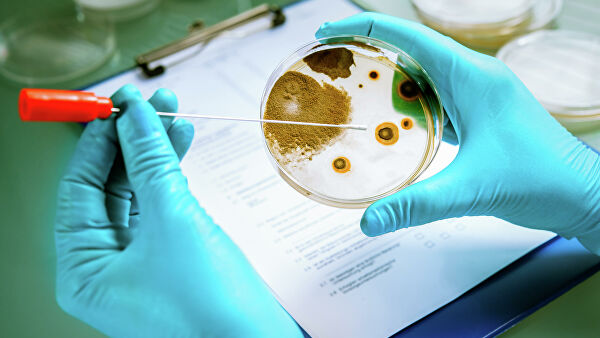
Вирусы вместо антибиотиков. Как бороться с суперинфекциями Вирусы вместо антибиотиков. Как бороться с суперинфекциями

Вирусы вместо антибиотиков. Как бороться с суперинфекциями
С некоторых пор болезнетворные бактерии стали вырабатывать устойчивость к антибиотику последнего резерва — колистину. Его применяют в тех случаях, когда остальные лекарства бессильны перед возбудителями инфекций. Неубиваемые микроорганизмы появились даже в Арктике, а Всемирная организация здравоохранения составила список из 12 наиболее опасных супербактерий, средство против которых необходимо найти уже сейчас.
Глобальная угроза
По данным британских исследователей, к 2050 году число смертей от антибиотикорезистентных супербактерий с сегодняшних семисот тысяч увеличится до десяти миллионов в год. Чаще всего люди, как считают специалисты ВОЗ, будут умирать от устойчивых к карбапенему энтеробактерий, синегнойной палочки (Pseudomonas aeruginosa) и ацинетобактера (Acinetobacter baumannii). Все эти возбудители связаны с так называемыми внутрибольничными инфекциями, которые пациенты цепляют в госпиталях и поликлиниках, где лечатся от других заболеваний.
Также среди наиболее опасных супербактерий, по данным ВОЗ, оказались энтерококки (Enterococcus faecium), золотистый стафилококк (MRSA), гонококк и устойчивый к кларитромицину хеликобактер — патогены, вызывающие менингит, заражение крови, пневмонию, гонорею и инфекции мочевыводящих путей.
Судя по эксперименту гарвардских ученых, невосприимчивость к лекарствам развивается у этих микроорганизмов стремительно. Обычная кишечная палочка Escherichia coli всего за 11 дней приспособилась к тысячекратной дозе антибиотиков и фактически превратилась в супермикроб, практически неуязвимый для любых существующих препаратов.
Найти новый антибиотик
Теоретически ученые способны создать лекарство против бактерий, нечувствительных к нынешним антибиотикам, однако его разработка и испытания могут занять долгие годы. А это, в свою очередь, может быть финансово невыгодно фармацевтическим компаниям.
Выход из сложившейся ситуации предложили исследователи из МФТИ, МГУ и Института биохимии и генетики РАН, придумавшие полуавтоматический метод поиска антибиотиков нового класса. Он основан на анализе того, как те или иные вещества действуют на патогенные микроорганизмы и уничтожают их. Ученые проверили действие почти 125 тысяч соединений на штамме кишечной палочки Escherichia coli и выявили 688 веществ, обладающих выраженной антибактериальной активностью. Некоторые из них обладали одинаковой подструктурной 2-пиразол-1-ил-тиазол группой. А значит, соединения, относящиеся к этому классу, могут быть эффективны в борьбе с лекарственно устойчивыми бактериями.Ученые раскрыли, почему стафилоккок больше не лечится антибиотикамиЗатем исследователи проанализировали принадлежащие к этой группе восемь молекул, которые уничтожали микроорганизмы, блокируя им синтез белка. Среди изученных веществ только одно не проявляло цитотоксического эффекта и гипотетически не представляло опасности для человека. Однако его еще следует тщательно исследовать и испытывать на модельных животных, отмечают авторы работы.
Вирусы против бактерий
Американские ученые предлагают бороться с микроорганизмами, устойчивыми к антибиотикам, с помощью бактериофагов — вирусов, избирательно поражающих бактериальные клетки. Правда, при такой терапии следует использовать частицы, созданные специально под определенный штамм возбудителя.
Специалисты уже помогли подобным образом пациентке, страдающей муковисцидозом и хронически инфицированной антибиотикорезистентным штаммом Mycobacterium abscessus. В начале 2018 года девушке провели двустороннюю трансплантацию легких, а потом обнаружили в анализах опасную микобактерию, спровоцировавшую загноение послеоперационной раны. Противомикробная терапия в течение семи месяцев не давала никаких результатов.Ученые нашли замену антибиотикамТогда ученые подобрали три фага, наиболее агрессивных по отношению к патогенному микроорганизму, смешали их и проверили действие созданного препарата на культуре штамма GD01 Mycobacterium abscessus, который был выделен у пациентки через месяц после операции. Полученная смесь не оставляла в живых ни одной бактерии, даже при высоких концентрациях.Затем комбинацию из трех бактериофагов в течение 32 недель внутривенно вводили пациентке каждые 12 часов. В результате ее состояние значительно улучшилось: послеоперационная рана стала заживать, а опасная бактерия больше не проявлялась в мокроте и крови.
Впрочем, авторы статьи предупреждают: говорить об эффективности лечения бактериофагами пока рано, ведь это единичный клинический случай. Тем не менее в медицинской литературе уже описана успешная терапия инфекций, вызванных супербактериями, с помощью антибиотиков и бактериофага. Вирусы могут играть роль второй «иммунной системы», заявляют ученые
Искусственные и эффективные
Китайские, американские и сингапурские ученые синтезировали вещество, способное разрушить сразу несколько бактерий, устойчивых к антибиотикам, — в том числе синегнойную палочку и золотистый стафилококк (MRSA). Речь идет о биоразлагаемом поликарбонатном полимере с гуанидиновыми функциональными группами, чьи молекулы могут связываться с бактериальной мембраной и, не разрушая ее, проникать внутрь клетки. Там гуанидин нарушает структуру белков цитоплазмы, и они выпадают в осадок, убивая бактерию.Исследователи протестировали новое лекарство на крысиных эритроцитах и клетках эмбриональных человеческих почек. Полимер оказался абсолютно нетоксичен для первых и менее ядовит для вторых, чем антибиотик полимиксин В, используемый сегодня в лечении бактериальных инфекций. Кроме того, новое соединение полностью разлагалось за трое суток, а продукты его распада были безвредны.

Молекула биоразлагаемого полимера, созданного учеными, способна связываться с бактериальной мембраной и проникать таким образом внутрь клетки. Там она денатурирует и высаживает в осадок белки цитоплазмы. В результате микроб погибаетКроме того, выяснилось, что созданный учеными полимер не вызывает привыкания у опасных микроорганизмов. Специалисты обрабатывали культуру Acinetobacter baumannii — возбудителя пневмонии — этим соединением в концентрациях, позволявших некоторым бактериям выживать. Затем из них выращивали новую культуру и снова обрабатывали ее поликарбонатом. И так тридцать раз подряд. Однако даже после этого микробы не выработали устойчивости к полимеру. Для сравнения: резистентность к антибиотику, который обычно применяют против Acinetobacter baumannii, бактерии выработали за восемь циклов.Авторы работы намерены в будущем протестировать созданный ими полимер на людях.

